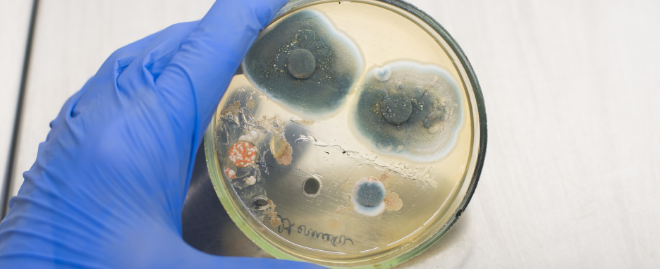
Mold in a petri dish

Signs You Should Consider a Mold Air Quality Test

Professional conducting an air quality test
MoldMold is a type of fungus that grows in damp or humid conditi... More can impact the indoor air qualityIndoor air quality (IAQ) refers to the condition of the air ... More of your property, causing building damage, health problems and more. When you actually can see the moldMold is a type of fungus that grows in damp or humid conditi... More in the house, it is pretty straight forward. But many times, moldMold is a type of fungus that grows in damp or humid conditi... More can grow in hidden places. If you don’t know whether there is moldMold is a type of fungus that grows in damp or humid conditi... More on your property, the first thing to do is to get a moldMold is a type of fungus that grows in damp or humid conditi... More air quality test.
MoldMold is a type of fungus that grows in damp or humid conditi... More tests can check for the air quality of the home and take swabs of moldMold is a type of fungus that grows in damp or humid conditi... More to the laboratory. It helps identify the source of the moldMold is a type of fungus that grows in damp or humid conditi... More and the amount of moldMold is a type of fungus that grows in damp or humid conditi... More present on the property, so professionals can determine whether the presence of moldMold is a type of fungus that grows in damp or humid conditi... More is abnormal.
So, you may be wondering when exactly you should consider a mold air quality test. Here are five reasons why you may want to contact a moldMold is a type of fungus that grows in damp or humid conditi... More testing professional:
Weird Smell or Odor in the House
MoldMold is a type of fungus that grows in damp or humid conditi... More has a distinct musty smell. Even when you don’t see any visible moldMold is a type of fungus that grows in damp or humid conditi... More on the property, you can detect the presence of moldMold is a type of fungus that grows in damp or humid conditi... More by the smell. When the smell is clearly present, it means that there is a concerning quantity of moldMold is a type of fungus that grows in damp or humid conditi... More. This is because moldMold is a type of fungus that grows in damp or humid conditi... More can grow on the interior of drywalls and other building materials. Getting a moldMold is a type of fungus that grows in damp or humid conditi... More test in this case can help determine the source of the moldMold is a type of fungus that grows in damp or humid conditi... More, so mold remediationMold remediation is the process of identifying, removing, an... More companies can take action to remove the moldMold is a type of fungus that grows in damp or humid conditi... More.
Allergies, Headaches or Other Health Concerns
People have different levels of sensitiveness to moldMold is a type of fungus that grows in damp or humid conditi... More. Some people with high sensitivity to moldMold is a type of fungus that grows in damp or humid conditi... More can exhibit various symptoms when exposed to moldMold is a type of fungus that grows in damp or humid conditi... More. Common symptoms of moldMold is a type of fungus that grows in damp or humid conditi... More exposure include headache, sneezing, coughing, throat irritation, respiratory problems and more. If you have some of these symptoms, moldMold is a type of fungus that grows in damp or humid conditi... More may be the reason why. Doctors may ask you to conduct a moldMold is a type of fungus that grows in damp or humid conditi... More air quality test to check if moldMold is a type of fungus that grows in damp or humid conditi... More is the reason for symptoms. You can also use this test for mold remediationMold remediation is the process of identifying, removing, an... More if moldMold is a type of fungus that grows in damp or humid conditi... More is actually the cause of the problems.
Previous Water or Mold Issues
If your property has suffered from water damage from leaky pipes, plumbing issues or from other reasons, moldMold is a type of fungus that grows in damp or humid conditi... More could be present on your property. Water can soak deep inside walls and floors, making it the perfect place for moldMold is a type of fungus that grows in damp or humid conditi... More to grow. After the water damage has been fixed, it would be a good time to conduct a moldMold is a type of fungus that grows in damp or humid conditi... More air quality test to make sure nothing will damage the property further.
Similarly, if your property previously had some moldMold is a type of fungus that grows in damp or humid conditi... More problems, it is always good to check to see if moldMold is a type of fungus that grows in damp or humid conditi... More has come back. The moldMold is a type of fungus that grows in damp or humid conditi... More air quality test can tell you whether the moldMold is a type of fungus that grows in damp or humid conditi... More issue is completely solved.
Home Inspection Purposes
Whether you are renting out or selling a property, checking the air quality for moldMold is a type of fungus that grows in damp or humid conditi... More is important. Renters could be interested in the air quality of the home when they are more sensitive to moldMold is a type of fungus that grows in damp or humid conditi... More. MoldMold is a type of fungus that grows in damp or humid conditi... More testing can help avoid other problems that might come up during the renting process. When selling or buying a property, moldMold is a type of fungus that grows in damp or humid conditi... More air quality tests could be included in the home inspectionInspection is the careful examination and assessment of a pr... More process to ensure that the house meets the standard.
Presence of Visible Mold
The most obvious sign is that there is visible moldMold is a type of fungus that grows in damp or humid conditi... More you can see on the property. When there is visible moldMold is a type of fungus that grows in damp or humid conditi... More, it usually means that there is hidden moldMold is a type of fungus that grows in damp or humid conditi... More in more places you cannot see. A professional with specialized equipment can help you determine exactly where the moldMold is a type of fungus that grows in damp or humid conditi... More is located and form a plan of removal.
Contact a Mold Air Quality Testing Professional
If any of the reasons above apply to you, you should consider calling a certified mold testing professional. A certified moldMold is a type of fungus that grows in damp or humid conditi... More testing professional can test moldMold is a type of fungus that grows in damp or humid conditi... More or microbial growth on commercial and residential properties. The test can detect the presence, the type, and the total count of the moldMold is a type of fungus that grows in damp or humid conditi... More sporesSpores are microscopic reproductive units of fungi or mold t... More to determine whether it is normal. If you need moldMold is a type of fungus that grows in damp or humid conditi... More removal services, you can use the results of the moldMold is a type of fungus that grows in damp or humid conditi... More test to reach out to a mold remediationMold remediation is the process of identifying, removing, an... More professional to take care of the moldMold is a type of fungus that grows in damp or humid conditi... More.








